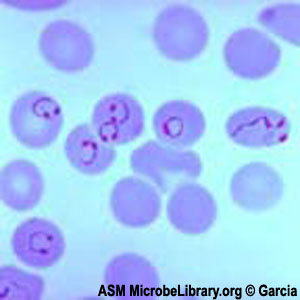
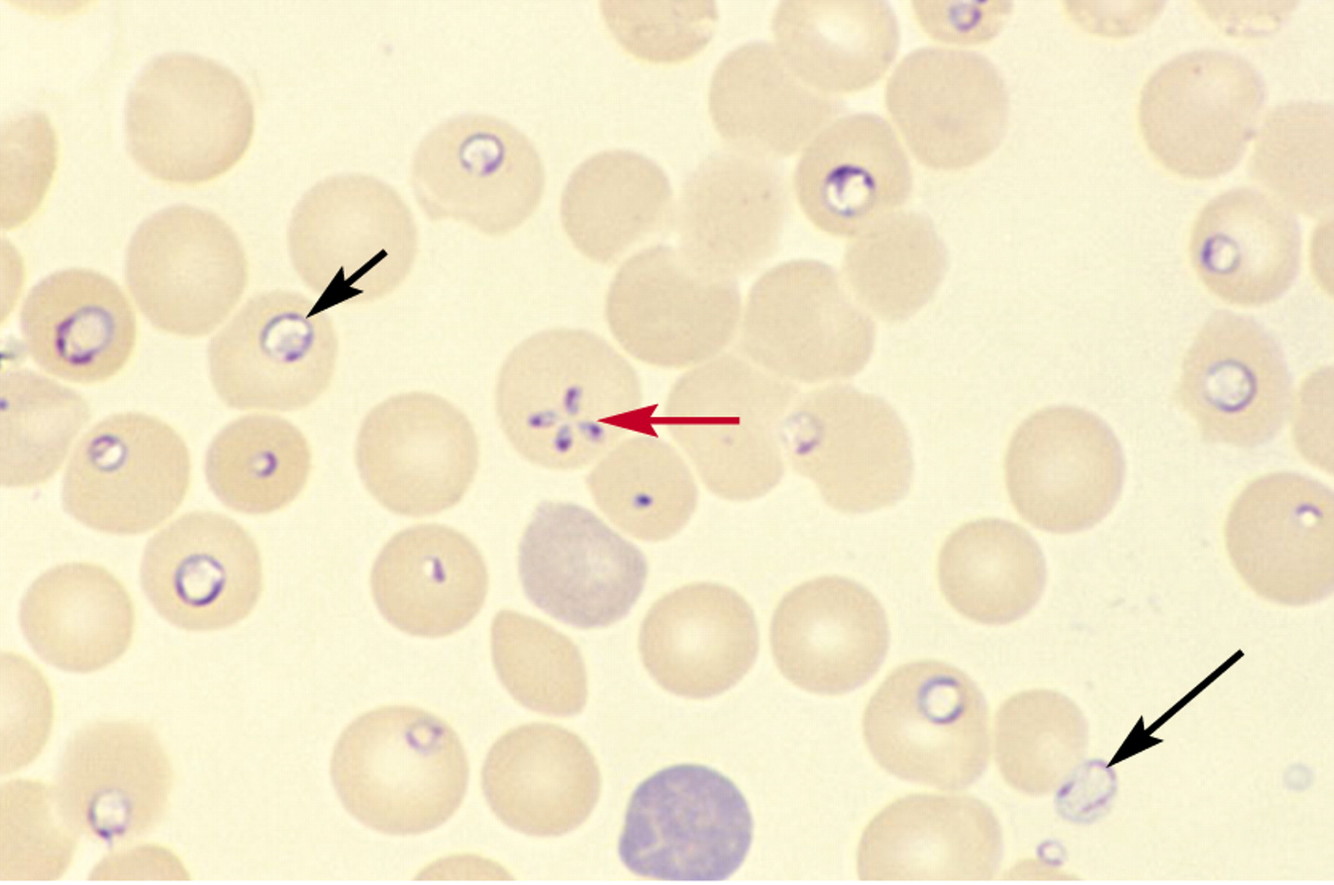
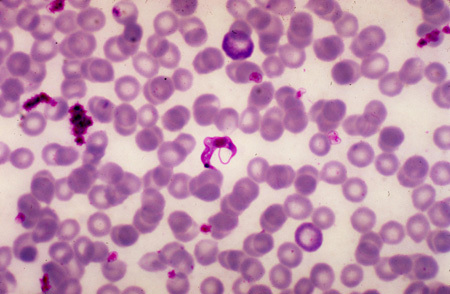

What are the 3 protozoa that cause GI infections?
Giardia lamblia (cysts in water)
Entamoeba histolytica (cysts in water)
Cryptosporidium (oocytes in water)
Trophozoites or cysts in the stool of a camper with fatty, foul-smelling diarrhea is indicative of what?
Giradia - Metronidazole
Trophozoites with RBCS in the cytoplasm found in the stool of a patient with bloody diarrhea, liver abscess and RUQ pain is indicative of what?
Entameoba histolytica
What is this?

Entamoeba histoltyica - Metronidazole
Brain abscess in HIV - ring enhancing lesions - is indicative of what disease? How is it transimted?
Toxoplasma gondii - cysts in meat or oocytes in cat feces
Sulfadiazine + pyrimethamine
What does congenital toxo look like?
Chorioretinitis
Hydrocephalus
Intracranial calcification
How might you contract naegleria fowleri
Swimming in freshwater lakes - enters thru cribiform plate
Rapidly fatal meningoencephalitis
Amphotericin B
A person with enlarged LN, recurring fever progressing to somnolence and coma is indicative of what?
Trypanosoma brucei = African Sleeping Sickness
Tsetse fly - blood smear
Suramin - blood borne
Melarsoprol - CNS
What does this patient have? What are possible sequelae?
Trophozoite rings - Plasmodium
Occulde capillaries in brain, kidneys, lungs
How do you treat plasmodium?
Chlorquine: Meflloquine or atovoquone/progaunil if resistant
+ Primaquine for hypnozoite
What does a patient with fever and hemolytic anemia and this blood smear have? How did they get it? How do you treat it?
Babesia - Ixodes tick
Atovaquone + Azithromycin
“maltese cross and ring form”
What is a patient with T. cruzi at increased risk for developing?
Dilated CM
Megacolon
Achalasia
What does this patient have? How did they get it? How do you treat it?
Chagas disease - T cruzi
Reduvid bug
Benznidazole or nifurtimox
A patient with these macrophages, spiking fevers, HSmegaly, and pancytopenia is infected with what?

Leishmania donovani - Sandfly
Amphotericin B
Mφ containing amastigotes
A patient with vaginitis: foul-smelling, greenish discharge, and strawberry cervix has what? How did they get it? How do you treat it?

Trichomonas vaginalis
STD - can’t exist outside humans - can’t form cysts
Metronidazole patient and partner
Biliary tract disease, cholangiocarcinoma
Clnorchis sinensis
Brain cysts, seizures
Taenia solium (cysticercosis)
Praziquantel, albendazole (neuro)
Painless hematuria, bladder cancer
Portal HTN
Schistosoma haematobium
Liver (hydatid) cysts
Echinococcus granulosus
(dog feces)
anaphylaxis if released - ethanol to kill
Microcytic anemia
IDA
Ancylostoma duodenale, Necator
Bendazole/pyrantel pamoate
Peripana pruritis
Enterobius - pinworm
Bendazoles
Ingested
Portal HTN
Schistosoma mansoni
Schistosoma japonicum
Vitamin B12 deficiency
Diphyllobothrium latum